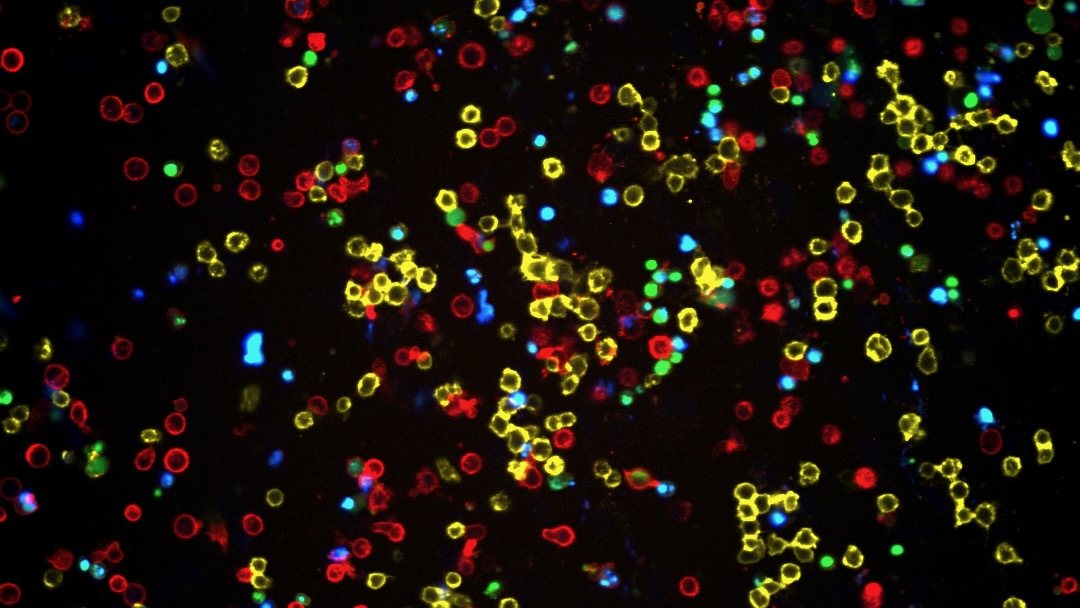

Zwei neue Nationale Forschungsschwerpunkte an der UZH
Mit Nationalen Forschungsschwerpunkten fördert der Bund interdisziplinäre Forschungsprojekte von strategischer Bedeutung. Zwei dieser Grossprojekte sind neu an der UZH angesiedelt.

Der Bund fördert interdisziplinäre Forschungsprojekte von strategischer Bedeutung über eine Laufzeit von maximal zwölf Jahren als Nationale Forschungsschwerpunkte (NFS). Nun wurden sechs neue NFS für den Zeitraum von 2026 bis 2038 bestimmt. Zwei der prestigeträchtigen Grossprojekte sind an der UZH angesiedelt: «Children & Cancer» (UZH und Universität Lausanne) und «Muoniverse» (Paul Scherrer Institut PSI und UZH).
Weitere Informationen finden Sie im Artikel der UZH News.